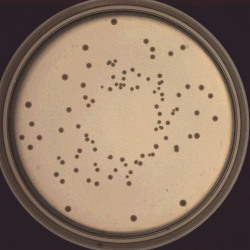
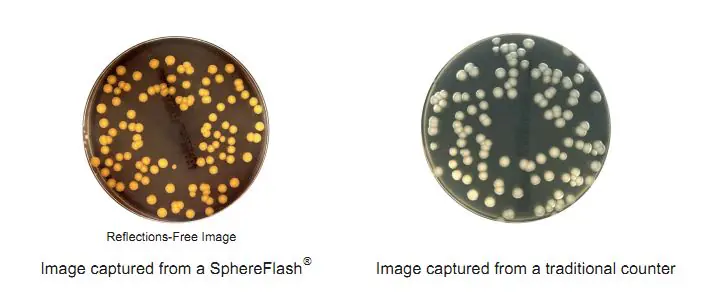
Sphere vs regular counter
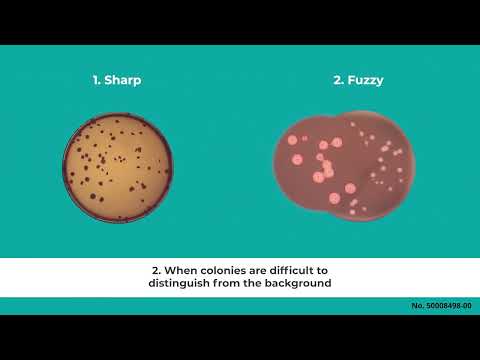

Automated Colony Counter – SphereFlash®
Counts Colonies in few seconds with few tiers of software to choose from
Description
Frequently used in various industries such as food pharma and personal care through research and development, the automatic colony counter has become the industry standard for the quality-control process.
In addition to producing highly accurate colony counts, the automated colony counter alleviates the high regulatory burden faced by most life science industries, as keeping an accurate audit trail simplifies compliance. The SphereFlash® automated colony counter can produce and retain records of the original plate image as well as the colony-counting algorithm design and threshold settings.
The traceability of colony counting decisions made by automated colony counters is useful for audits, while enabling laboratory personnel to target and eliminate error sources. The chief value this digital audit trail serves is to assist with maintaining CFR 21 Part 11 compliance for pharmaceutical and medical device laboratories.
Neutec Group introduces the SphereFlash® – an automated colony counter that grows and adapts to your specific microbiology lab needs. It can be upgraded at any time to fit the level of automation, security and features required. With numerous SphereFlash® colony counter units installed in a variety of microbiology laboratories in industries such as Environmental, Food, Pharma, Biotech, etc., the IUL new SphereFlash® automatic colony counter utilizes cutting edge technology lighting conditions and intelligent software that make the day to day work easier than ever. Find out more information about the benefits of using a colony counter over manual colony counts here.

Modern LED illumination, combined with a unique patent pending sphere that operates as a perfect closed environment for best light and image taking conditions. The smart but user-friendly colony counting software (installed on Windows 7, 8.1 or 10 Based computers) together with a high resolution camera, all make for a powerful affordable automatic colony counter system.
It cannot be overstated that because colony counting determines how many microbial colonies are propagating on culture media, such as agar plates, accurate counts become imperative. The SphereFlash® automated colony counter is an example of a newer technology that utilizes digital imaging and machine learning algorithms to provide a high-throughput alternative to manual colony counting. Since colony counting has applications ranging from product testing in various industries such as food pharma and personal care through research and development, the SphereFlash® offers additional benefits to laboratory technicians who may have increased colony counting assignments. The greater the need for increased accuracy, higher throughput, and regulatory compliance, the greater the need for the SphereFlash® automated colony counters.
Detailed IQ/OQ validation protocols are available to ensure compliance with Good Laboratory Practice (GLP) and that results meet regulatory requirements.
Customer success story: See what our customer, food microbiologist, Kelsey Lamb has to say here about the SphereFlash.
To help you transition from manual colony counting to automated colony counting and calculate Cost Savings and Return on Investment R.O.I press here


The SphereFlash® counts the majority of colonies on various media. Its high-resolution color camera can detect and count colonies of approx. 1/450 inch (0.07mm). The new patented illumination device enables processing of any media type, including transparent/opaque agar, without interference from ambient light sources as the sphere goes down and creates an isolated environment.
The SphereFlash® automated colony counter’s modular approach enables laboratories to automate their colony counting processes, inhibition zone measuring, and upgrade them to a higher level of sophistication as necessary- all within a budget.
Sphere Flash Lite can be upgraded to the Colonies Pro Software at any time to provide an addition of unlimited protocols, user management, result table customization and an audit trail.
Lite Automatic Colony Counter – Hardware and software- Cat. No. 90007000
- For counting Pour and Spiral plates in a few seconds
- Every count under control: add or eliminate colonies with one click on the screen
- Delete an area by a simple draw with the mouse or with the touch screen pen
- Automatic calibration and varification
- Add saved protocols as needed
- Optimize detection with a single bar
- Result table Customozition
- Remote input output mode (LIMS)
- User friendly colony counting software
- Report generation
- Dimes: 28.8L*22W*37.1H cm, 11.3″L*8.66″W*14.6″
- Audit trail (CFR21Part11)
SphereFlash® Colonies Pro Software is designed for more demanding users who require increased capabilities such as setting user’s permission levels, LIMs connectivity, working with worksheets, Barcode reading, reporting, audit trail and CFR21Part 11 compliance.
SphereFlash Colonies PRO Automatic Colony Counter software upgrade – Cat. No. 90007001
- For counting Pour and Spiral plates in a few seconds
- Every count under control: add or eliminate colonies with one click on the screen
- Delete an area by a simple draw with the mouse or with the touch screen pen
- Automatic calibration and verification
- Add saved protocols as needed
- Optimize detection with a single bar
- Result table Customization
- Remote input output mode (Lims)
- User friendly colony counting software
- Report generation
- Dimes: 28.8L*22W*37.1H cm, 11.3″L*8.66″W*14.6″
- Audit trail (CFR21Part11)
SphereFlash AI – cat. No. 90007003 and 90007004 – NEW !

- A single click is all that stands between uploading the image and obtaining the result
- Image captured, uploads to the cloud and processed instantly (internet connectivity required)
- State of the art quality of counting results and ease of use
- We offer different tiers of images packages per year
- Request your trial demo of 100 plates today !

Manual colony counting involves visually distinguishing bacterial colonies based on their size and shape, while adding to a mental or written count. Unfortunately, manual colony counting is subject to human error and research bias.
Further, if a microbiologist expects a specific experimental outcome, that bias can affect the count. Difficulty distinguishing between 2 colonies or mistakes in double-counting or missing colonies can lead to less accurate colony counts. Fortunately, there is another key obstacle with manual counts that does not exist with the SphereFlash® automatic colony counter.
One of the most common errors in manual colony counting is failing to distinguish between two colonies with overlapping edges. As a digital imaging tool, the SphereFlash® detects these minor or subtle color gradations that indicate edge overlap. Manual colony counters often look at a fraction of a plate, such as a quarter, and extrapolate that count to the entire plate by multiplying the results.
The SphereFlash® automatic colony counter counts the colonies on most of the plate surface, which leads to more accurate counts. An added benefit is that automated colony counters can record additional data, like colony size and color, that manual colony counts would be unable to measure with any objectivity.

Hardware minimum Requirements for the Sphere Flash colony counter
| Processor | Minimum | Intel i3 or similar |
| Recommended | Intel i5, i7 or similar | |
| RAM Memory | Minimum | 4 GB |
| Recommended | 8 GB | |
| Hard disk | 100 MB of free disk space and 100GB for Data | |
| Communication | 1 free USB 3.0 (blue connector) | |
| Human Interface Devices | Keyboard and Microsoft Mouse or compatible pointing device (Including Tablet PC Touch panels) | |
| Internet connectivity | A plus for best remote support and training | |
| Microsoft Windows ® 7 , 8.1, 10 64 bits .MS Excel ® (not included) is required to open Excel files |
Download Center
Download Sphere Flash Catalog
Fort Valley Uni. Evaluation of the Flash & Go Colony counter Vs. Manual counts